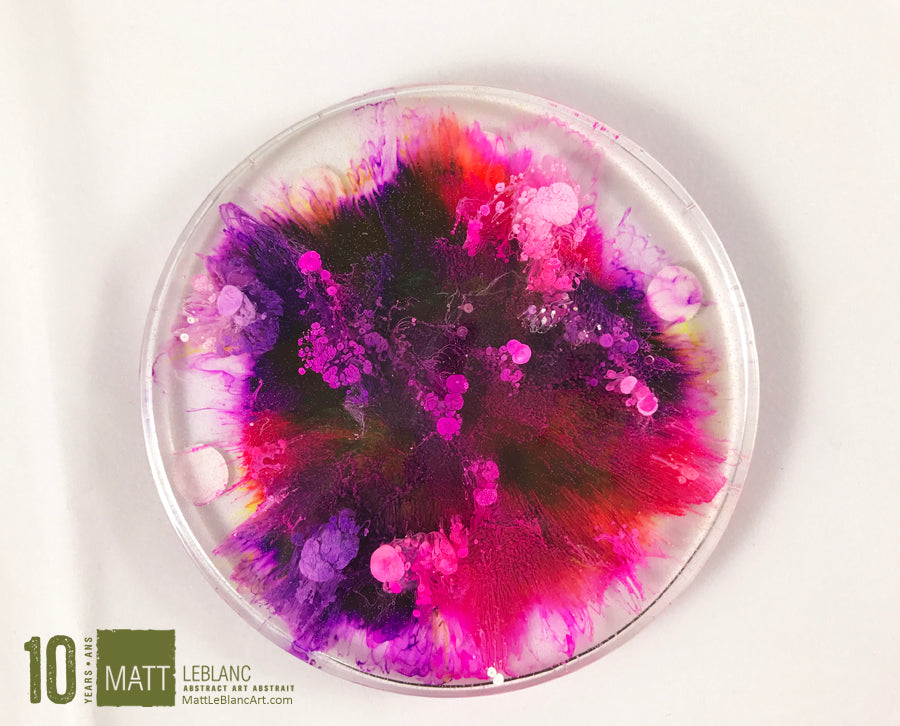
Matt LeBlanc Supernova Art - 3.5" round - 0006

Matt LeBlanc Art
Matt LeBlanc Supernova Art - 3.5" round - 0006
Type: original round see-through supernova art by Matt LeBlanc
Size: Approximately 3.5" round x 1/2" deep
Cost: Buy this original Supernova Art for $20 + $5 of shipping. The product comes with a clear adjustable easel stand.
About Matt LeBlanc
Matt LeBlanc has come from virtual anonymity in his home province of New Brunswick, to become one of the most popular artists in eastern Canada and beyond. His unique blend of art and commerce has allowed LeBlanc to sell over 3,000 paintings in more then 20 countries in less then seven years.
His work has been featured in various home decor magazines, blogs and on various TV shows airing on HGTV Canada. Matt’s ability to design a unique piece of art based on his clients’ current décor has been a big asset in developing his strong brand as an artist. His art is also owned by reputable people like Debbie Travis, Kevin O’Leary, Clara Hughes and Ron Buist among many more.
Please click HERE to learn more about Matt Leblanc